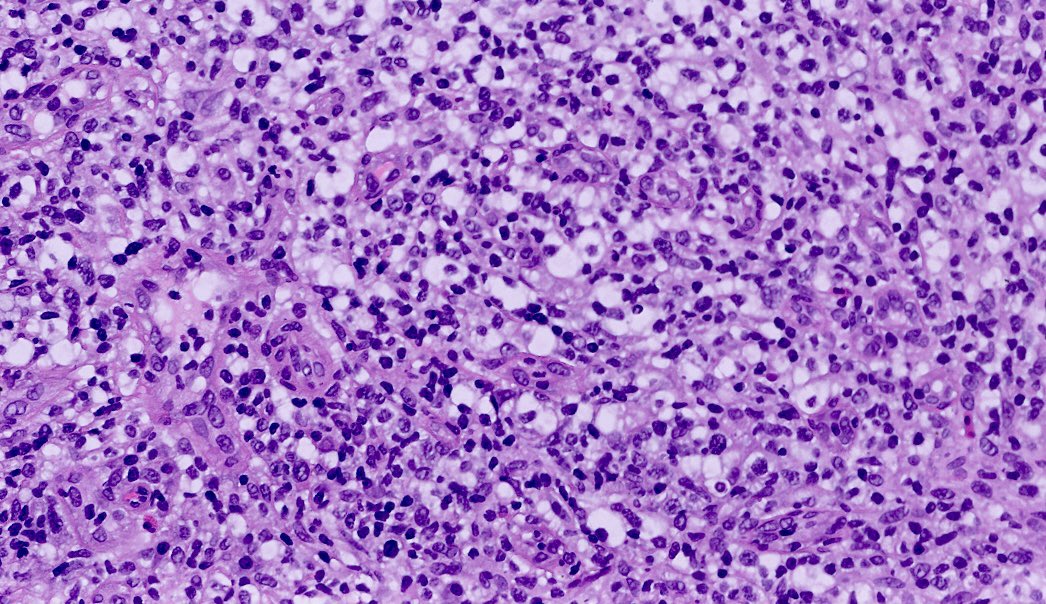
Shachar Path tweet media
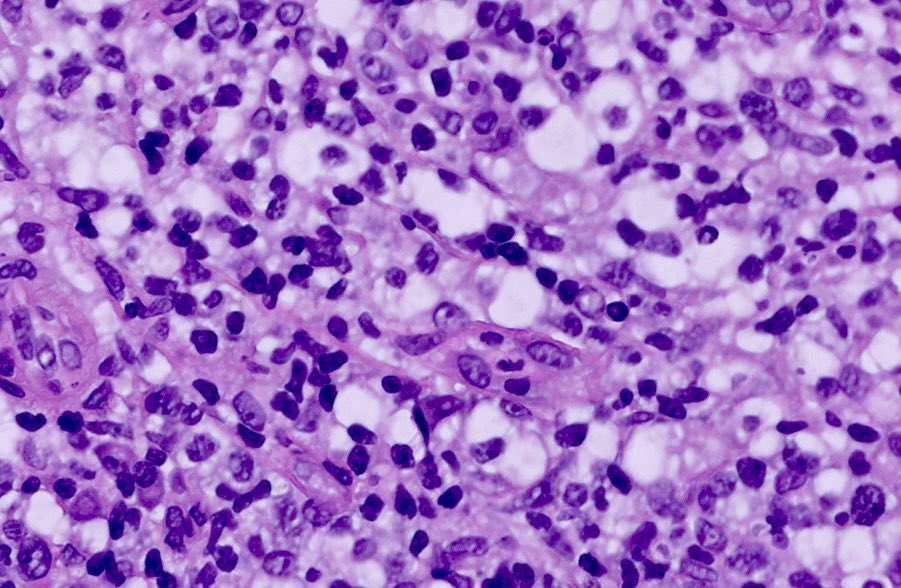
Shachar Path tweet media

Jeff
1.4K posts

Jeff
@redb56
#Pathology and music. Baldwin-Wallace class of 1978, Yale School of Music 1982 and Columbia College of Physicians and Sugeons 1993. #hematopathology #hemepath
Kent, Connecticut Katılım Temmuz 2012
3.6K Takip Edilen2.1K Takipçiler

Donald Trump, at almost 80, is going to die sooner than we think.
Bookmark this. When Trump passes, there will be an absolute ORGY of grotesque delight on the Left and even among moderates. They will celebrate in the streets and hold parties. It will be a macabre display, such as we've never seen yet.
It will make their celebration of Charlie Kirk's murder look like your great aunt Mildred's church tea party.
Mark my words.
English

@TheRhetorRick I get it, but I’ve been wired to despise the Oxford comma. I know, clarity etc. but it gives me the fantods.
English

@krassenstein She is absolutely bipolar crazy. I think she needs lithium and a quiet room, and not speaking in public and asking politicians ridiculous questions.
English

BREAKING: republican Nancy Mace once again shows that she’s obsessed with asking people “what is a woman”?
Governor Walz has the perfect response.
Why are these people so obsessed over all this transgender stuff? I just don’t get how this impacts any of us in any way. There’s literally a war going on and the nation is almost $40 trillion in debt, and this is what they care about.
English

@TheRhetorRick @HansFiene Which is very true, even though while I’m sitting there a billion colors, emotions and thoughts fly through my brain like I’m on acid. But, I’m still quiet.
English

@HansFiene How about only classical music concerts.
Because everyone stays seated and quiet so you can actually hear and enjoy the music you paid to come hear.
English

The best way to determine where you fall on the introvert/extrovert spectrum is by looking at your preferred live music experience.
No concert ever: social anxiety disorder
Secluded pavilion acoustic set: girl introvert
Violent mosh pit: boy introvert
Stadium show: extrovert
Stadium show where you stand up all night shouting “woo”: psychotic
Me? I’m “formal attire seated in a theater with music at a reasonable volume and dignified clapping” aka mild introvert.
English

BREAKING: New video of Oklahoma’s @SenMullin trying yo forcibly take Rep. Al Green’s “BLACK PEOPLE ARE NOT APES” sign.
It’s weird how he was so angry about a truthful sign.
English

@TheRhetorRick I'm concerned because I can't figure out if you are being sarcastic or sincere.
English

@TheRhetorRick @PowerLunch_biz And refusing ALL transfusion of blood products no matter what the situation.
English

@PowerLunch_biz We should protect people from HIV by instituting and enforcing laws against homosexual behavior.
English

every time a right winger crows about leftists being hate-filled, i'm going to remember item 83375802 in Conservatives being Sociopaths, "woman definer" threatening to kill gay men

Paul@WomanDefiner
It's all fun and games until we stop federally funding PREP medications for the gay community.
English

@TheRhetorRick But then do you HAVE to watch that crap that comes before and after it?
English

Sentinel lymph node for frozen section.
Diagnosis?
From a carcinoma resection. Remote history of large cell lymphoma.
If metastatic carcinoma, then immediate lymph node dissection.
#PathX #PathTwitter



English

@RealBrittHughes Tell your loved one to get another job. One that helps America.
English

@Lynda4NJPatriot Ha ha! I can't wait until ALL pediatricians do this!! Get out of my waiting room!!
English

@StandUpForTrmp I can’t use that word in this forum, comerade. You know that.
English

@MericaCulture Well done, comerade! Got any more secrets to sell to Russia on you?
English

@MdBreathe Should make for a pretty worm free state. About the best can say about it…
English

@TheRhetorRick Does anyone know the secret about getting this stuff out of a bottle anymore, or do we just squeeze now because it’s so easy and we must be satisfied immediately ?
English

There is a third superior way, known only to the wise, and involving this exact type of ketchup bottle...

𝐌𝐚𝐭𝐭 𝐏𝐢𝐧𝐧𝐞𝐫@Matt_Pinner
Which Type are You? 🍟😃
English

@MericaCulture Yeah yesh, it’s ALL we boomers fault. Go soak your head in a barrel, comerade.
English

@TheRhetorRick When you consider the uproar over “Le Déjeuner sur l'herbe” and the Rite of Spring, these seem rather blasé. I’ve performed 4’33” before, it goes over well with audiences but I think it’s more of a work for the performer’s mind.
English

@Hot_Pepper76 In a coffeehouse Sebastian sat, and after every number they’d pass the hat…
English